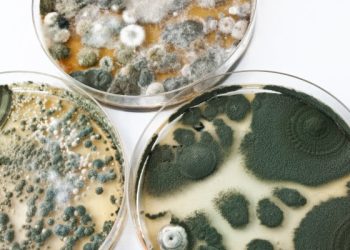
Cannabis Cultivators Need to Go Above and Beyond to Test for and Remove Deadly Mycotoxins

Product Refinement
Product Refinement stage focuses on enhancing the quality, purity, and potency of extracts. It's essential for producing market-ready products that meet regulatory standards and your customers' expectations. In Extraction Magazine, we cover the latest in refinement technology and all the applicable methods. Detailed analyses of techniques, chromatography, solvent recovery, and decarboxylation. Our goal is to help professionals optimize their refinement processes and ultimately help you to make sure these processes are efficient, compliant, and capable of scaling to meet market demands.
Short Path Distillation
The Science Thereof Making crude cannabis extracts is all well and good. Put some material in a column, run solvent...
Ardent Nova Decarboxylator
The Ardent Nova Decarboxylator is an innovative product which resembles a mini portable oven. It’s specifically designed to decarboxylate cannabis...
Benefits of Cannabis Extraction
The extraction of cannabis predates the industrial age by almost a century. The intake of cannabis resin — hashish —...
Separation of CBD from THC
Besides leading the cannabis parade in terms of beneficial and coveted qualities, CBD and THC are also stand very close...
Cannabis Cultivators Need to Go Above and Beyond to Test for and Remove Deadly Mycotoxins
Mycotoxins are pharmacologically active metabolites that are born out of fungi. Some mycotoxins are used to produce antibiotics. Other mycotoxins...